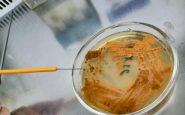
featured 2214071

Roma, 22 mag. (Adnkronos Salute) – Un gruppo di ricerca internazionale coordinato dall'università degli Studi dell'Insubria, guidato da Flavia Marinelli del Dipartimento di Biotecnologie e scienze della vita, ha scoperto un nuovo antibiotico glicopeptidico – chiamato dal team kineomicina – che si è dimostrato promettente per la sua capacità di inibire la crescita di batteri patogeni attualmente resistenti alle terapie antibiotiche comunemente utilizzate.
"L'antibiotico-resistenza – ricorda Marinelli, da anni impegnata nello studio di nuove molecole di origine microbica per combatterla – è quel fenomeno che si verifica quando i farmaci utilizzati per contrastare i batteri, ovvero gli antibiotici, smettono di essere efficaci. E' riconosciuta dall'Organizzazione mondiale della sanità come una pandemia silenziosa che oggi minaccia la salute globale, rischiando di compromettere decenni di progressi in campo medico: dal trattamento di una semplice infezione all'impossibilità di effettuare interventi chirurgici complessi.
Più di 35mila persone muoiono ogni anno in Europa a causa dell'antibiotico-resistenza. E' pertanto urgente scoprire nuovi antibiotici, utilizzando tutti gli approcci possibili che la comunità scientifica ha a disposizione".
Il lavoro – recentemente pubblicato su 'Communications Chemistry', rivista del Nature Portfolio – ha mostrato come, grazie a un approccio in silico basato sull'analisi bioinformatica di grandi quantità di dati sulla diversità microbica, sia stato possibile predire la struttura chimica di un nuovo antibiotico prodotto da un microrganismo esotico: l'Actinokineospora auranticolor.
Il bioinformatico coinvolto nel progetto è Oleksandr Yushchuk, per molti anni postdoc ospite del Laboratorio di Biotecnologie microbiche di UnInsubria, che ha poi dovuto fare ritorno a Lviv allo scoppio della guerra in Ucraina. La collaborazione è però continuata nonostante il conflitto, permettendo al gruppo di biotecnologi microbici insubrici, coordinati da Francesca Berini, di produrre nei fermentatori dell'ateneo la nuova molecola.
Hanno partecipato al progetto anche gruppi di ricerca delle università tedesche di Berlino e Bielefeld. Roderich Süssmuth (università tecnica di Berlino) ha collaborato alla delucidazione della struttura chimica del nuovo antibiotico, mentre Jörn Kalinowski (università di Bielefeld) ha contribuito alla caratterizzazione genomica del microrganismo produttore.
"La strada verso un possibile sviluppo della kineomicina come nuovo farmaco è appena iniziata – si legge in una nota – e richiederà numerosi ulteriori studi, sia in vitro sia in vivo. Tuttavia questa scoperta conferma che, grazie a nuovi approcci multidisciplinari, è possibile trovare nelle risorse naturali – in questo caso nella straordinaria diversità metabolica dei microrganismi – nuove soluzioni per affrontare le infezioni multiresistenti".